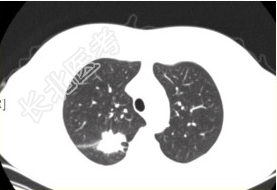

试题详情
- [材料题] 患者女,54岁,无症状,常规体检透视时发现右上肺阴影。既往无结核病史。体格检查阴性。CT结果如下图。

- 多项选择题1.本病例可见的征象包括
A、分叶征
B、毛刺征
C、胸膜凹陷征
D、空泡征
E、含气支气管征
F、钙化
关注下方微信公众号,搜题查看答案

- 多项选择题2.该例最可能诊断为
A、肺结核瘢痕
B、周围型肺癌
C、肺错构瘤
D、肺腺瘤
E、结核球
F、尘肺(硅沉着病)
关注下方微信公众号,搜题查看答案

- 多项选择题3.最易出现分叶状边缘的肺癌类型是
A、鳞癌
B、腺癌
C、未分化癌
D、肺泡癌
E、转移性肿瘤
F、肺类癌
关注下方微信公众号,搜题查看答案

- 多项选择题4.易出现空洞的肺癌类型是
A、鳞癌
B、腺癌
C、未分化癌
D、肺泡癌
E、转移性肿瘤
F、肺类癌
关注下方微信公众号,搜题查看答案

- 多项选择题5.局限性阻塞性肺气肿最常见的病因是
A、支气管哮喘
B、支气管扩张
C、慢性支气管炎
D、大叶性肺炎
E、支气管肺癌
F、支气管囊肿
关注下方微信公众号,搜题查看答案

热门试题
- 神经鞘瘤的典型CT表现为A、圆形实质性肿
- 1、提高CT空间分辨力的方法不包括2、关
- 1、本病最可能诊断为2、本病诊断依据为3
- 前臂前后位摄片,中心线投射方法是 (
- 1、根据上述病例,拟考虑的疾病是2、为进
- 与CT相比,MRI有哪些优点A、多参数成
- 1、颈椎张口位照片显示,以下错误的是2、
- 男,38岁, 左侧腮腺渐进性肿大1年,无
- 蛛网膜下腔出血的典型CT表现A、脑沟、脑
- 主要的脂肪抑制技术是A、STIRB、化学
- 1、首选的检查方法为A、CTB、MRIC
- 干式激光胶片保存注意事项包括A、24℃以
- 属于DSA介入治疗技术的是A、栓塞术B、
- 常规CT扫描中不用于控制图像层厚的是A、
- 以下关于磁共振图像矩阵的叙述,不正确的是
- 骨肉瘤的X线表现有A、溶骨性破坏B、瘤骨
- 穿刺插管所致并发症包括A、穿刺部位血肿B
- 关于CT扫描,叙述错误的是A、对于不能合
- 下列描述,正确的是 ( )A、
- 下列能够产生磁共振现象的原子是A、1H